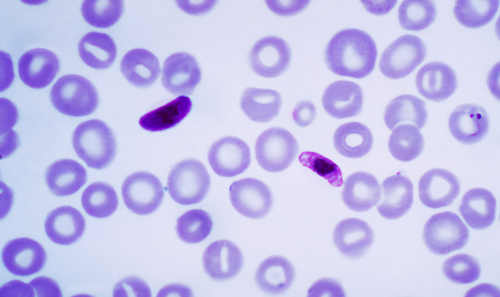
Protista Mirip Hewan (Protozoa) dan Contohnya Materi Biologi

Kelompok protista mirip jamur memiliki spora.
Jika kamu sedang mencari artikel kelompok protista mirip jamur memiliki spora terlengkap, berarti kamu sudah berada di website yang tepat. Yuk langsung saja kita simak penjelasan kelompok protista mirip jamur memiliki spora berikut ini.
 Biologi dan Sejarah Protista Mirip Jamur From sosialitasworld.blogspot.com
Biologi dan Sejarah Protista Mirip Jamur From sosialitasworld.blogspot.com
Sebagian besar dari kelompok protista memiliki sifat parasit, sedangkan sebagian lainnya bermanfaat bagi manusia.
Berdasarkan kajian biologi molekuler, organisme ini ternyata berhubungan lebih dekat dengan alga coklat dan diatom daripada dengan fungi. Protista yang menyerupai jamur ini mempunyai struktur tubuh dan cara reproduksi yang tidak sama dengan kelompok fungi. Protista mirip jamur tidak dimasukkan dalam kelompok jamur karena struktur tubuh dan cara reproduksinya berbeda dengan jamur. Protista mirip jamur adalah kelompok protista jamur air dan jamur lendir. Ciri protista mirip jamur by diki posted on 26 june 2021 20 september 2021 beberapa kelompok jamur tidak dikelompokkan ke dalam dunia pfungi, tetapi dikelompokan ke dalam dunia protista, sebab pada satu tahap dalam daur hidupnya, yaitu pada fase vegetatif, jamur tersebut mempu bergerak seperti protozoa.
 Source: blogkumpulanmateribiologi.blogspot.com
Source: blogkumpulanmateribiologi.blogspot.com
Protista mirip tumbuhan uniseluler sering disebut sebagai. Spora seksual dihasilkan secara singami. Sebagian besar dari kelompok protista memiliki sifat parasit, sedangkan sebagian lainnya bermanfaat bagi manusia. Protista dibedakan menjadi tiga kelompok, yaitu protista yang mirip hewan mampu bergerak secara aktif, protista yang mirip tumbuhan mampu berfotosintesis, sedangkan protista yang menyerupai jamur memiliki. Protista mirip jamur tidak dimasukkan dalam kelompok jamur karena struktur tubuh dan cara reproduksinya berbeda dengan jamur.
Protista mirip jamur dikelompokkan dalam 2 filum (kelas), yaitu jamur lendir (myxomycota) dan jamur air (oomycota).
Berdasarkan kajian biologi molekuler, organisme ini ternyata berhubungan lebih dekat dengan alga coklat dan diatom daripada dengan fungi. Akan tetapi, protista mirip jamur memiliki beberapa ciri yag sama dengan jamur, yaitu mempunyai struktur yang menghasilkan spora, bersifat heterotrof, dan hidup sebagai parasit atau pengurai dengan mengeluarkan enzim. Klasifikasi protista mirip jamur (slime mold) menurut armansyah (2014), protista mirip jamur dibagi menjadi tiga kelompok diantaranya sebagai berikut. Oleh karena itu, jamur lendir dan jamur air di masukkan ke dalam kelompok protista mirip jamur.protista mirip jamur secara umum dibedakan menjadi 2 filum yaitu filum jamur lendir (mycomycota) dan filum jamur air (oomycota).
 Source: sosialitasworld.blogspot.com
Source: sosialitasworld.blogspot.com
Zigot jamur lendir dapat bergerak (motil) karena memiliki bulu cambuk (flagellum). Belum memiliki akar, batang, dan daun sejati. Berdasarkan kajian biologi molekuler, organisme ini ternyata berhubungan lebih dekat dengan alga coklat dan diatom daripada dengan fungi. Spora seksual dihasilkan secara singami.
 Source: slideshare.net
Source: slideshare.net
Cara reproduksi jamur lendir hampir sama dengan fungi, tetapi tidak dapat dikelompokkan dalam kingdom fungi karena gerakan pada fase aseksualnya lebih mirip dengan amoeba. Sementara itu, jamur air lebih menyerupai ganggang pada struktur molekulnya, hanya saja tidak mengandung klorofil. Demikian pula, tidak memiliki klorofil, sehingga bersifat heterotrofik (mengambil makanan dari makhluk hidup lainnya). Protista yang menyerupai hewan (protozoa) protista yang menyerupai tumbuhan (protophyta) protista yang menyerupai jamur.
 Source: slideshare.net
Source: slideshare.net
Jamur kelompok protista ini selnya motil (bergerak) yang berciri memiliki dua flagella tidak sama panjang. Spora seksual dihasilkan secara singami. Pada tahun 1886,seorang ahli biologi jerman bernama ernst haeckel memperkenalkan kingdom ketiga yang disebut protista untuk menempatkan organisme yang bukan hewan ataupun tumbuhan. Myxomycetes (jamur lendir tidak bersekat) jamur ini memiliki beberap sifat yang mirip dengan jamur sejati.
Kelompok protista dan jamur ini hidup di daerah yang lembab.
Jamur lendir tidak memiliki klorofil. Singgami terdiri dari dua tahap, yaitu tahap plasmogami dan tahap kariogami. Reproduksi jamur secara seksual dilakukan oleh spora seksual. Oomycetes yang dikenal juga dengan jamur air merupakan kelompok. Sebagian besar dari kelompok protista memiliki sifat parasit, sedangkan sebagian lainnya bermanfaat bagi manusia.
 Source: sosialitasworld.blogspot.com
Source: sosialitasworld.blogspot.com
Singgami terdiri dari dua tahap, yaitu tahap plasmogami dan tahap kariogami. Dikatakan mirip tumbuhan karena bersifat autotrof dan memiliki klorofil. Jamur air secara fisik mirip dengan fungi. Jamur dibagi menjadi 6 filum, yaitu : Nah, pada kesempatan kali ini kita akan belajar mengenai klasifikasi, contoh, dan peranan organisme yang masuk dalam kelompok protista mirip jamur.
Zigot jamur lendir dapat bergerak (motil) karena memiliki bulu cambuk (flagellum).
Reproduksi jamur secara seksual dilakukan oleh spora seksual. Myxomycota adalah kelompok jenis jamur lendir yang berwarna kuning karena memiliki pigmen berwarna kuning atau oranye. Jamur air atau oomycota adalah kelompok protista uniseluler yang berfilamen. Myxomycota (jamur lendir) myxomycota disebut dengan jamur lendir karena memiliki protoplasma tanpa dinding sel.
 Source: sosialitasworld.blogspot.com
Source: sosialitasworld.blogspot.com
Secara umum, protista dibedakan menjadi 3 kelompok yaitu protista mirip hewan (protozoa) protista mirip tumbuhan (alga) dan protista mirip jamur (oomycota) protista mirip hewan atau protozoa. Protista yang menyerupai jamur ini mempunyai struktur tubuh dan cara reproduksi yang tidak sama dengan kelompok fungi. Sebagai pengurai, jamur akan mengeluarkan enzim. Sementara itu, jamur air lebih menyerupai ganggang pada struktur molekulnya, hanya saja tidak mengandung klorofil.
 Source: slideshare.net
Source: slideshare.net
Myxomycota adalah kelompok jenis jamur lendir yang berwarna kuning karena memiliki pigmen berwarna kuning atau oranye. Akan tetapi, protista mirip jamur memiliki beberapa ciri yag sama dengan jamur, yaitu mempunyai struktur yang menghasilkan spora, bersifat heterotrof, dan hidup sebagai parasit atau pengurai dengan mengeluarkan enzim. Protista yang menyerupai jamur ini mempunyai struktur tubuh dan cara reproduksi yang tidak sama dengan kelompok fungi. Jamur dibagi menjadi 6 filum, yaitu :
 Source: slideshare.net
Source: slideshare.net
Cara reproduksi jamur lendir hampir sama dengan fungi, tetapi tidak dapat dikelompokkan dalam kingdom fungi karena gerakan pada fase aseksualnya lebih mirip dengan amoeba. Berdasarkan alat geraknya hewan bersel satu dibagi menjadi: Reproduksi jamur secara seksual dilakukan oleh spora seksual. Jamur lendir tidak dapat menghasilkan spora.
Memiliki klorofil yang terdapat pirenoid yang berfungsi membentuk amilum.
Spora seksual dihasilkan secara singami. Memiliki klorofil yang terdapat pirenoid yang berfungsi membentuk amilum. Kingdom protista adalah kelompok organisme yang memiliki struktur sel eukariotik, uniseluler maupun multiseluler, tidak memiliki jaringan yang sebenarnya dan tidak termasuk hewan, tumbuhan, dan fungi. Belum memiliki akar, batang, dan daun sejati. Myxomycetes (jamur lendir tidak bersekat) jamur ini memiliki beberap sifat yang mirip dengan jamur sejati.
Source: blogkumpulanmateribiologi.blogspot.com
Source: blogkumpulanmateribiologi.blogspot.com
Jamur lendir tidak memiliki klorofil. Jamur air atau oomycota adalah kelompok protista uniseluler yang berfilamen. Cara reproduksi jamur lendir hampir sama dengan fungi, tetapi tidak dapat dikelompokkan dalam kingdom fungi karena gerakan pada fase aseksualnya lebih mirip dengan amoeba. Singgami terdiri dari dua tahap, yaitu tahap plasmogami dan tahap kariogami. Enzim ini memecah atau merombak senyawa organik yang dihasilkan.
Protista dibedakan menjadi tiga kelompok, yaitu protista yang mirip hewan mampu bergerak secara aktif, protista yang mirip tumbuhan mampu berfotosintesis, sedangkan protista yang menyerupai jamur memiliki.
Protista dibedakan menjadi tiga kelompok, yaitu protista yang mirip hewan mampu bergerak secara aktif, protista yang mirip tumbuhan mampu berfotosintesis, sedangkan protista yang menyerupai jamur memiliki. Oomycetes yang dikenal juga dengan jamur air merupakan kelompok. Klasifikasi fungi pada klasifikasi 5 kingdom, myxomycota dan oomycota termasuk kelompok protista, yaitu protista mirip jamur. Belum memiliki akar, batang, dan daun sejati.
 Source: slideshare.net
Source: slideshare.net
Ciri protista mirip jamur by diki posted on 26 june 2021 20 september 2021 beberapa kelompok jamur tidak dikelompokkan ke dalam dunia pfungi, tetapi dikelompokan ke dalam dunia protista, sebab pada satu tahap dalam daur hidupnya, yaitu pada fase vegetatif, jamur tersebut mempu bergerak seperti protozoa. Jamur air secara fisik mirip dengan fungi. Myxomycota adalah kelompok jenis jamur lendir yang berwarna kuning karena memiliki pigmen berwarna kuning atau oranye. Ciri protista mirip jamur by diki posted on 26 june 2021 20 september 2021 beberapa kelompok jamur tidak dikelompokkan ke dalam dunia pfungi, tetapi dikelompokan ke dalam dunia protista, sebab pada satu tahap dalam daur hidupnya, yaitu pada fase vegetatif, jamur tersebut mempu bergerak seperti protozoa.
 Source: mikirbae.com
Source: mikirbae.com
Hewan berkaki semu tumbuhnya membentuk kaki contoh amoeba proteus. Jamur air secara fisik mirip dengan fungi. Protista mirip jamur tidak dimasukkan dalam kelompok jamur karena struktur tubuh dan cara reproduksinya berbeda dengan jamur. Protista dibedakan menjadi tiga kelompok, yaitu protista yang mirip hewan mampu bergerak secara aktif, protista yang mirip tumbuhan mampu berfotosintesis, sedangkan protista yang menyerupai jamur memiliki.
 Source: slideshare.net
Source: slideshare.net
Demikian pula, tidak memiliki klorofil, sehingga bersifat heterotrofik (mengambil makanan dari makhluk hidup lainnya). Berdasarkan kajian biologi molekuler, organisme ini ternyata berhubungan lebih dekat dengan alga coklat dan diatom daripada dengan fungi. Akan tetapi, protista mirip jamur memiliki beberapa ciri yag sama dengan jamur, yaitu mempunyai struktur yang menghasilkan spora, bersifat heterotrof, dan hidup sebagai parasit atau pengurai dengan mengeluarkan enzim. Pada tahun 1886,seorang ahli biologi jerman bernama ernst haeckel memperkenalkan kingdom ketiga yang disebut protista untuk menempatkan organisme yang bukan hewan ataupun tumbuhan.
Akan tetapi, protista mirip jamur memiliki beberapa ciri yag sama dengan jamur, yaitu mempunyai struktur yang menghasilkan spora, bersifat heterotrof, dan hidup sebagai parasit atau pengurai dengan mengeluarkan enzim.
Oleh karena itu, jamur lendir dan jamur air di masukkan ke dalam kelompok protista mirip jamur.protista mirip jamur secara umum dibedakan menjadi 2 filum yaitu filum jamur lendir (mycomycota) dan filum jamur air (oomycota). Cara reproduksi jamur lendir hampir sama dengan fungi, tetapi tidak dapat dikelompokkan dalam kingdom fungi karena gerakan pada fase aseksualnya lebih mirip dengan amoeba. Dikatakan mirip tumbuhan karena bersifat autotrof dan memiliki klorofil. Sebagai pengurai, jamur akan mengeluarkan enzim. Singgami terdiri dari dua tahap, yaitu tahap plasmogami dan tahap kariogami.
 Source: slideshare.net
Source: slideshare.net
Myxomycetes (jamur lendir tidak bersekat) jamur ini memiliki beberap sifat yang mirip dengan jamur sejati. Nama “jamur air” yang diberikan berdasarkan fakta bahwa mereka tumbuh dengan baik dalam kondisi kelembaban yang tinggi dan berair. Sementara itu, jamur air lebih menyerupai ganggang pada struktur molekulnya, hanya saja tidak mengandung klorofil. Protista mirip jamur adalah kelompok protista jamur air dan jamur lendir. Singgami terdiri dari dua tahap, yaitu tahap plasmogami dan tahap kariogami.
Oleh karena itu, jamur lendir dan jamur air di masukkan ke dalam kelompok protista mirip jamur.protista mirip jamur secara umum dibedakan menjadi 2 filum yaitu filum jamur lendir (mycomycota) dan filum jamur air (oomycota).
Secara umum, protista dibedakan menjadi 3 kelompok yaitu protista mirip hewan (protozoa) protista mirip tumbuhan (alga) dan protista mirip jamur (oomycota) protista mirip hewan atau protozoa. Jamur lendir tidak memiliki klorofil. Protista yang menyerupai hewan (protozoa) protista yang menyerupai tumbuhan (protophyta) protista yang menyerupai jamur. Oleh karena itu, jamur lendir dan jamur air di masukkan ke dalam kelompok protista mirip jamur.protista mirip jamur secara umum dibedakan menjadi 2 filum yaitu filum jamur lendir (mycomycota) dan filum jamur air (oomycota).
 Source: slideshare.net
Source: slideshare.net
Oleh karena itu, jamur lendir dan jamur air di masukkan ke dalam kelompok protista mirip jamur.protista mirip jamur secara umum dibedakan menjadi 2 filum yaitu filum jamur lendir (mycomycota) dan filum jamur air (oomycota). Protista dibedakan menjadi tiga kelompok, yaitu protista yang mirip hewan mampu bergerak secara aktif, protista yang mirip tumbuhan mampu berfotosintesis, sedangkan protista yang menyerupai jamur memiliki. Belum memiliki akar, batang, dan daun sejati. Dikatakan mirip tumbuhan karena bersifat autotrof dan memiliki klorofil. Kingdom protista adalah kelompok organisme yang memiliki struktur sel eukariotik, uniseluler maupun multiseluler, tidak memiliki jaringan yang sebenarnya dan tidak termasuk hewan, tumbuhan, dan fungi.
 Source: sosialitasworld.blogspot.com
Source: sosialitasworld.blogspot.com
Enzim ini memecah atau merombak senyawa organik yang dihasilkan. Soal pilihan ganda + jawabannya biologi kelas 10 bab 6 protista.pembaca sekolahmuonline, berikut ini kami sajikan contoh soal pilihan ganda lengkap dengan jawabannya mata pelajaran biologi kelas x bab 6 yang membahas tentang protista. Nah, pada kesempatan kali ini kita akan belajar mengenai klasifikasi, contoh, dan peranan organisme yang masuk dalam kelompok protista mirip jamur. Protista mirip jamur dikelompokkan dalam 2 filum (kelas), yaitu jamur lendir (myxomycota) dan jamur air (oomycota). Jamur lendir tidak memiliki klorofil.
 Source: slideshare.net
Source: slideshare.net
Singgami terdiri dari dua tahap, yaitu tahap plasmogami dan tahap kariogami. Protista mirip jamur dikelompokkan dalam 2 filum (kelas), yaitu jamur lendir (myxomycota) dan jamur air (oomycota). Pada tahun 1886,seorang ahli biologi jerman bernama ernst haeckel memperkenalkan kingdom ketiga yang disebut protista untuk menempatkan organisme yang bukan hewan ataupun tumbuhan. Berdasarkan alat geraknya hewan bersel satu dibagi menjadi: Ciri protista mirip jamur by diki posted on 26 june 2021 20 september 2021 beberapa kelompok jamur tidak dikelompokkan ke dalam dunia pfungi, tetapi dikelompokan ke dalam dunia protista, sebab pada satu tahap dalam daur hidupnya, yaitu pada fase vegetatif, jamur tersebut mempu bergerak seperti protozoa.
Situs ini adalah komunitas terbuka bagi pengguna untuk mencurahkan apa yang mereka cari di internet, semua konten atau gambar di situs web ini hanya untuk penggunaan pribadi, sangat dilarang untuk menggunakan artikel ini untuk tujuan komersial, jika Anda adalah penulisnya dan menemukan gambar ini dibagikan tanpa izin Anda, silakan ajukan laporan DMCA kepada Kami.
Jika Anda menemukan situs ini baik, tolong dukung kami dengan membagikan postingan ini ke akun media sosial seperti Facebook, Instagram dan sebagainya atau bisa juga bookmark halaman blog ini dengan judul kelompok protista mirip jamur memiliki spora dengan menggunakan Ctrl + D untuk perangkat laptop dengan sistem operasi Windows atau Command + D untuk laptop dengan sistem operasi Apple. Jika Anda menggunakan smartphone, Anda juga dapat menggunakan menu laci dari browser yang Anda gunakan. Baik itu sistem operasi Windows, Mac, iOS, atau Android, Anda tetap dapat menandai situs web ini.





